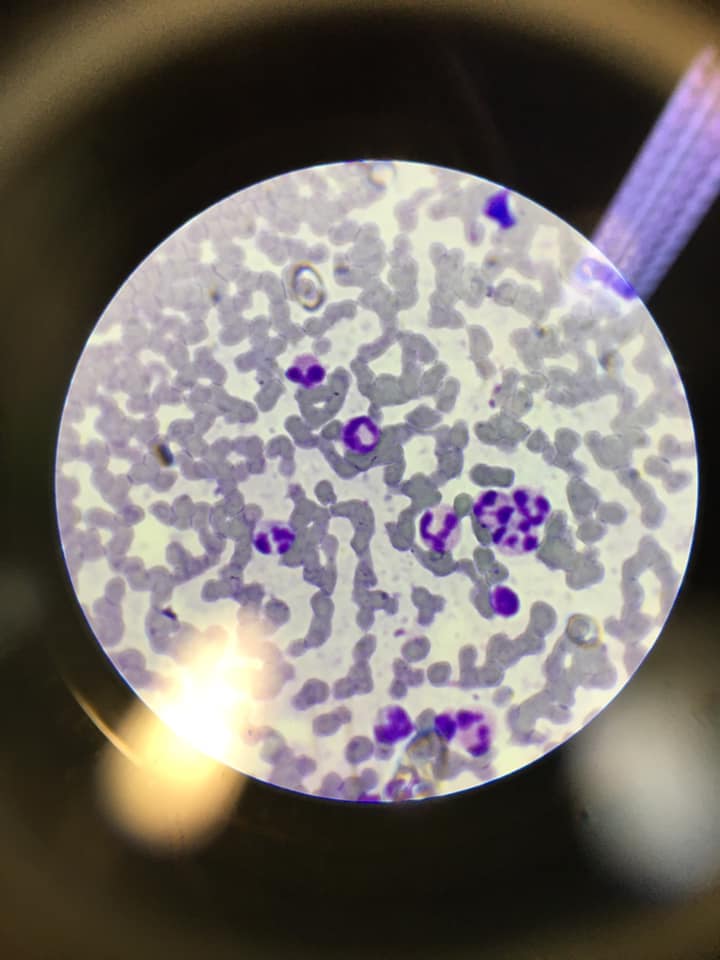

Dierenkliniek Sint Anna 404 heeft een eigen laboratorium waar verschillende onderzoeken worden uitgevoerd.
Niet alles wat er is kun je met het blote oog zien
Uitgebreid urineonderzoek en ontlastingsonderzoek op bijvoorbeeld giardia, longworm of wormen wordt in onze kliniek uitgevoerd.
Bloedonderzoek
Voorafgaand aan de narcose wordt ter plekke bloedonderzoek uitgevoerd gericht op de vitale functies die van belang zijn voor de narcose.
Voor zieke dieren beschikken wij ook over uitgebreide mogelijkheden om het bloed te onderzoeken. Het grootste voordeel van onze eigen bloedapparatuur is de snelheid waarmee de uitslag bekend is. Meestal zal de dierenarts dezelfde of de volgende dag al een behandelplan kunnen maken.
Voor huidklachten is er dermatologisch onderzoek mogelijk naar bacteriën en gisten op de huid en in oren. De glaasjes met het te onderzoeken materiaal worden gekleurd en onder de microscoop bekeken. Parasieten zoals mijten en luizen zien we ook met behulp van de microscoop.
Extern laboratorium
Iedere dag komt er een koerier om materialen voor extern onderzoek op te halen. Zo kan het zijn dat er aanvullende bloedtesten worden aangevraagd, uitgebreid ontlastingsonderzoek nodig is, of dat er stukjes weefsel naar de patholoog gaan. Voor deze aanvullende onderzoeken werken wij nauw samen met een veterinair laboratorium.